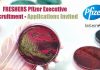
FRESHERS Pfizer Executive Recruitment – Applications Invited Freshers Pfizer Executive Recruitment

CSIR-CIMAP Project Research Associate Jobs, Attend Walk-In
CSIR-CIMAP Project Research Associate Jobs, Attend Walk-In
CSIR-CIMAP Project Research Associate Jobs, Attend Walk-In. Government jobs for MSc & PhD Botany/Biochemistry/Biotechnology/Microbiology/ Plant Science. Interested and...
Cancer Research Institute, ACTREC Postdoc Positions Available
Postdoc Jobs ACTREC CRI - PhD Candidates Apply
Postdoc Jobs ACTREC CRI - PhD Candidates Apply. PhD Molecular Biology Jobs. Postdoctoral jobs at ACTREC. Interested...
TMC HBCH-MPMMCC Trial Coordinator Recruitment, Attend Walk-In
TMC Trial Coordinator Jobs For Life Science, Clinical Research
TMC Trial Coordinator Jobs For Life Science, Clinical Research. MSc with PG Diploma Life Sciences, Biotech,...
Python Basics Certification Course Schedule – Programming For Biologists Series
Python Basics Certification Course Schedule - Coding For Biologists Series
Dear Biotecnikans,
👉 Read More - Why Biologists Should Learn Python With Biotecnika? A Look at...
AIIMS Delhi MSc/MTech/PhD Life Sciences Epigenetics Study Project Recruitment
AIIMS Delhi Project Recruitment For MSc/MTech/PhD Life Sciences
AIIMS Delhi Project Recruitment For MSc/MTech/PhD Life Sciences. AIIMS New Delhi Junior Research Fellow Recruitment. AIIMS New...
Pfizer Publications Writer For Life Sciences – MSc & PhD Apply Online
Pfizer Publications Writer For Life Sciences - MSc & PhD Apply Online
Pfizer Publications Writer For Life Sciences - MSc & PhD Apply Online. Pfizer...
GATE BT Question Discussion Schedule – FREE & Exclusively on Biotecnika App
GATE BT Question Discussion Schedule - FREE & Exclusively on Biotecnika App
Dear Biotecnikans,
Please find the schedule of the classes for the GATE BT Question...
Ferrero Officer Production System Development Job For Food Tech
Ferrero Officer Production System Development Job For Food Tech
Ferrero Officer Production System Development Job For Food Tech. BSc & MSc Food Technology Officer...
JNCASR MBGU Unit R&D Assistant Job For Biotech, Biology & Life Sciences
JNCASR Biotech R&D Assistant Job - Biology & Life Sciences Apply
JNCASR Biotech R&D Assistant Job - Biology & Life Sciences Apply. MSc in Biology/Biotechnology/...
IIT Guwahati Biotech & Life Sciences JRF (GATE) Recruitment
IIT Guwahati Biotech & Life Sciences JRF (GATE) Recruitment
IIT Guwahati Biotech & Life Sciences JRF (GATE) Recruitment. IIT Guwahati is hiring Biotechnology & Life...
PGIMER SRF Recruitment For MSc Life Sciences, Applications Invited
PGIMER SRF Recruitment For MSc Life Sciences, Applications Invited
PGIMER SRF Recruitment For MSc Life Sciences, Applications Invited. PGIMER MSc Life-Sciences Senior Research Fellow Jobs....
RCB Life Sciences Project Assistant Job For MSc & MTech, Apply Online
RCB Job MSc MTech Life Sciences, Apply Online
RCB Job MSc MTech Life Sciences, Apply Online. MSc & MTech Life Sciences Project Assistant Job. Interested...
WB Health DHFW Molecular Biologist Job With Rs. 40,000 pm Pay, Attend Walk-In
DHFW Molecular Biologist Job With Rs. 40,000 pm Pay, Attend Walk-In
DHFW Molecular Biologist Job With Rs. 40,000 pm Pay, Attend Walk-In. MSc Molecular Biology/Microbiology/...
Project Associate-1 Position in DBT Funded Project at Yenepoya (Deemed to be University)
Project Associate-1 Position Vacant at Yenepoya (Deemed to be University)
Project Associate-1 Position Vacant at Yenepoya (Deemed to be University). DBT Funded Project Vacancy Available...
NCBS Biological Sciences Project Associate Recruitment, Apply Online
NCBS Biological Sciences Project Associate Recruitment, Apply Online
NCBS Biological Sciences Project Associate Recruitment, Apply Online. MSc Biological Sciences and BTech Biosciences project associate I...